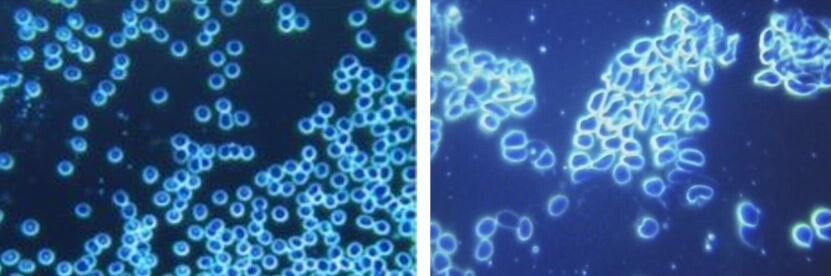

Het verliezen van een kind is het meest pijnlijke trauma dat een ouder ooit zal ervaren. Cornelia Hertzler uit Hot Springs, Montana, beviel op 3 januari 2022 van Alexander. Helaas overleed Alexander op 17 februari 2022. Mevrouw Hertzler vertelde The Gateway Pundit dat haar baby van een maand oud stierf aan een bloedstolsel veroorzaakt door het ontvangen van “COVID-gevaccineerd bloed” tijdens een bloedtransfusie. “Hij stierf na het krijgen van een bloedtransfusie van gevaccineerd bloed,” beweerde Hertzler. “Hij kreeg direct na zijn transfusie een bloedstolsel. Een bloedstolsel dat geen bloedverdunner kon oplossen.“

Baby Alexander voor en na de bloedtransfusie (Bron: Cornelia Hertzler)
“Het werd steeds erger totdat het van zijn knie naar zijn hart ging en zijn organen werden afgesloten. Daarom zwol zijn lichaam op en zagen zijn aderen eruit alsof ze explodeerden,” voegde ze eraan toe.
Alexander werd geboren met een keelprobleem dat alleen operatief behandeld kan worden. Hertzler beweerde dat haar zoon het bloed kreeg van de arts van het Heilig Hart in Spokane, Washington, zonder toestemming van haar of haar man. “Hij werd geopereerd om een probleem in zijn keel op te lossen waarmee hij was geboren. Hij had tijdens de operatie geen bloedtransfusie nodig. De meeste baby’s niet.”
“Later, nadat onze machtiging was verlopen (we hebben alleen toestemming gegeven voor een bloedtransfusie in geval van nood tijdens een operatie) gaf de dokter hem een bloedtransfusie omdat zijn hemoglobinegehalte een beetje laag was. We hadden hier geen toestemming voor gegeven en de dokter wist dat we geen gevaccineerd bloed wilden omdat we ons zorgen maakten over bloedstolsels. De volgende dag na de transfusie ontdekten ze een bloedstolsel,” zei Hertzler.
Hertzler verklaarde dat de arts de mogelijkheid had uitgesloten dat het incident werd veroorzaakt door de bloedtransfusie. “Ze wilden niet eens denken dat het de bloedtransfusie was die hem doodde. Ze gaven wel toe dat het het bloedstolsel was dat hem doodde. Ik hoop dat het anderen kan waarschuwen voor het gevaar van het bloed uit de bloedbank,” zei ze.

Volgens het Amerikaanse Rode Kruis (*) labelen ze “bloedproducten niet als bevattend gevaccineerd of niet-gevaccineerd bloed, omdat het COVID-19-vaccin niet in de bloedbaan komt en geen veiligheidsrisico’s voor de ontvanger vormt.“. “Terwijl de antilichamen die worden geproduceerd door het gestimuleerde immuunsysteem als reactie op vaccinatie in de bloedbaan worden aangetroffen, zijn de eigenlijke vaccincomponenten dat niet,” zei Jessa Merrill, de directeur van biomedische communicatie van het Rode Kruis.
De foto links bij 40x vergroting toont de bloedconditie van de patiënt vóór de inenting. De afbeelding rechts, ook bij 40x vergroting, toont de vervorming van het erytrocytencelprofiel en de sterke neiging van de misvormde erytrocyten om te aggregeren. (Bron: IJTPVR)
* Volgens een studie ondersteund door het ministerie van Onderzoek, Innovatie en Digitalisering van Roemenië en gepubliceerd op de NIH-website, kan het mRNA-vaccin 15 dagen na vaccinatie in bloed worden gedetecteerd, in tegenstelling tot de beweringen van het Rode Kruis. “Concluderend toonden we aan dat BNT162b2-vaccinmRNA gedurende ten minste 2 weken in de systemische circulatie van gevaccineerde personen blijft, gedurende welke het waarschijnlijk zijn vermogen behoudt om S-eiwitexpressie in gevoelige cellen en weefsels te induceren,” aldus de studie. “In plasma was mRNA onmiddellijk detecteerbaar op slechts enkele uren na vaccinatie, bleef detecteerbaar wanneer het werd bemonsterd na 6 en 15 dagen.” De Gateway Pundit meldde eerder dat een peer-reviewed studie in Italië aantoonde dat 94% van de mensen die bijwerkingen ondervonden na het ontvangen van mRNA-vaccins abnormaal bloed hadden en vreemde stoffen bevatten een maand na vaccinatie.
























































